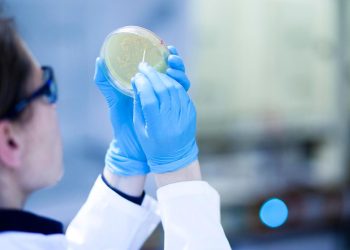
studie:-wenn-forschende-ihre-erkenntnisse-zurueckhalten

Studie: Wenn Forschende ihre Erkenntnisse zurückhalten
"Gollum-Effekt" Wenn Forschende ihre Erkenntnisse nicht teilen Stand: 06.06.2025 07:54 Uhr In der Wissenschaft werden Daten und Erkenntnisse oft zurückgehalten....
Evolution: Blütenpflanzen entstanden vor 123 Millionen Jahren
Stand: 07.06.2025 11:13 Uhr Die Entstehung der Blütenpflanzen kam einer Revolution in der Ökologie gleich. Doch wie und wann genau...
Wenn KI das biologische Alter berechnet
Stand: 15.06.2025 03:19 Uhr Wie fit ist mein Körper und wie alt werde ich? Diese Fragen könnte in Zukunft eine...
Gesund altern – aber wie?
Diskussionspapier vorgestellt Gesund altern - aber wie? Stand: 18.06.2025 16:17 Uhr Viele alte Menschen haben chronische Erkrankungen. Das könne man...
Wie eine Brasilianerin die Landwirtschaft verändert
Welternährungspreis Wie eine Brasilianerin die Landwirtschaft verändert Stand: 19.06.2025 13:41 Uhr Brasiliens Landwirtschaft hat keinen guten Ruf: Rodung von Wäldern,...
Sonnenfalten: Hält Sonnencreme unsere Haut jung?
Falten durch Sonne Hält Sonnencreme unsere Haut jung? Stand: 21.06.2025 06:03 Uhr Zu viel Sonne tut der Haut nicht gut:...
Was bei Schlafproblemen hilft – und was nicht
Stand: 21.06.2025 15:09 Uhr Je nach Studie leidet etwa jeder Vierte in Deutschland unter Schlafproblemen, jeder Zehnte unter Insomnie. Abhilfe...
KI-Modell erkennt mehr als 170 Krebsarten
Krebsmedizin Mit KI Tumore erkennen Stand: 23.06.2025 14:04 Uhr Ein neues KI-Modell der Berliner Charité erkennt mehr als 170 Tumorarten...
Kurze Nickerchen bringen mehr Gedankenblitze
Schlafforschung Mit kurzem Nickerchen zum Gedankenblitz Stand: 26.06.2025 20:10 Uhr Manchmal sitzt man vor einer Aufgabe und kommt einfach nicht...
Wie Roboter in der Pflege helfen können
Stand: 27.06.2025 01:39 Uhr Immer mehr Pflegebedürftige, immer weniger Pflegepersonal: Bis Roboter Pflegekräfte entlasten können, wird es noch dauern. Das...
BROWSE BY CATEGORIES
BROWSE BY TOPICS
POPULAR NEWS
-
Wie die erste E-Mail nach Deutschland kam
-
So funktioniert die Richterwahl für das Bundesverfassungsgericht
-
Rekorde dank Nvidia, Walt Disney mit Kimmel-Comeback – der Tag an der Wall Street
-
Palantir: Zwischen Rheinmetall und LVMH
-
Die vergessenen Schnäppchen – das sind die 16 Aktien-Favoriten der Profis